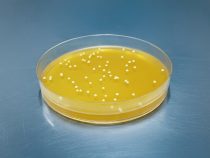
Príbeh kvasiniek: Od kuchyne k Nobelovej cene

Na počiatku bol príbeh
Veda sa začína príbehmi. Ich vzťah sa prelína dejinami myslenia. Vyvíjal sa od prvých mýtických kozmológií až po súčasné formy špekulatívnej fikcie, ktoré sa snažia predpovedať následky moderných technológií. Príbeh nemusí byť iba o vede; môže byť sám vedou. Nie je to len popularizačný doplnok,… pokračuj